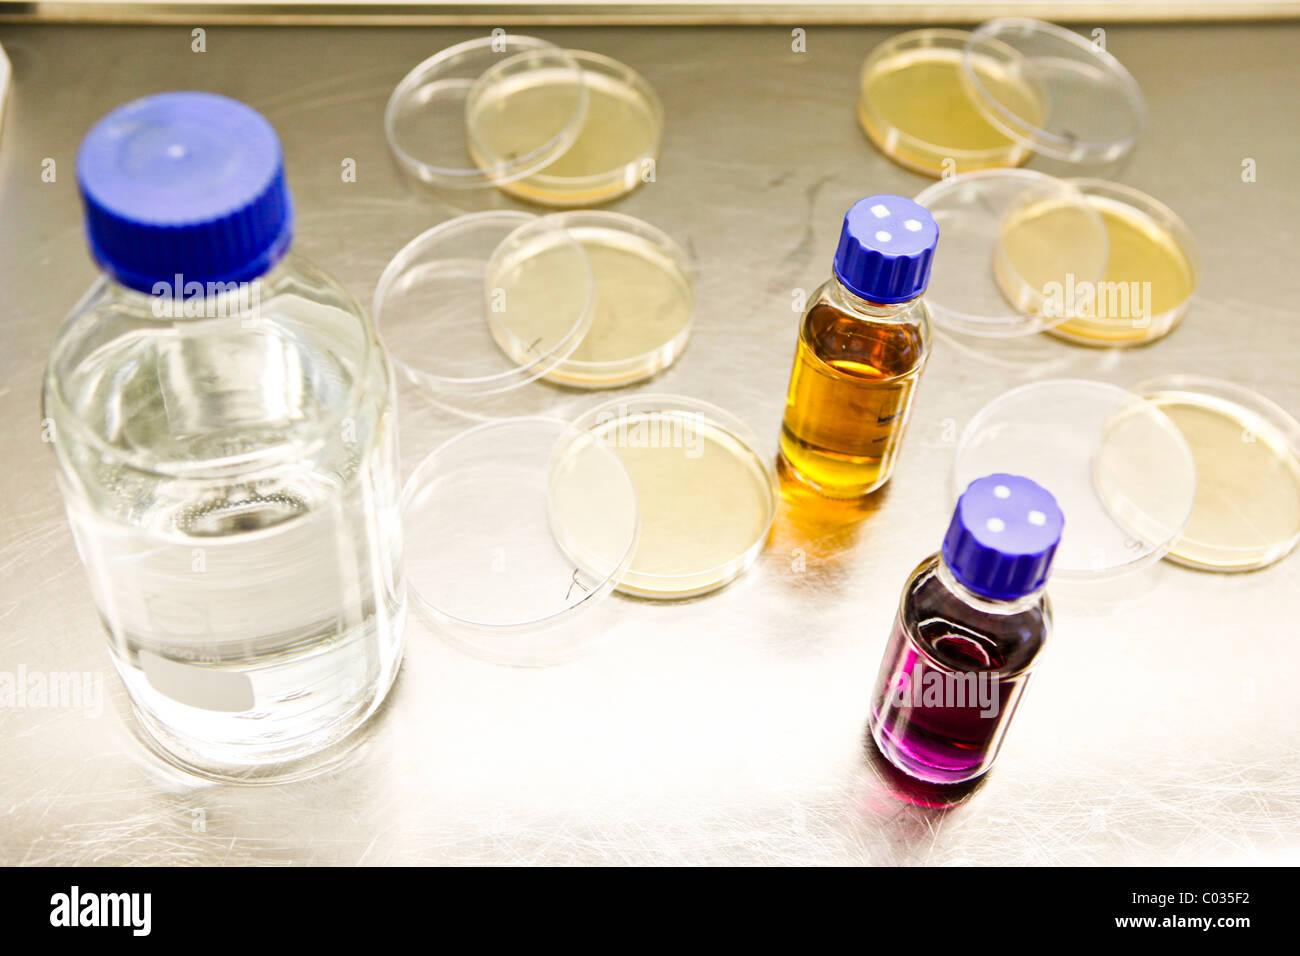
Industria farmaceutica, le colture in vitro Foto Stock

In vitro Immagini Stock
(7,789)Filtri rapidi:
In vitro Immagini Stock

RFR4C45F–La modifica genetica in vitro CRISPR genetica Ingegneria genomica biotecnologia medica health care concetto con un uovo umano fecondato embrione.

RMBM600T–Clinica privata per la fecondazione in vitro. La fecondazione artificiale. Lo sperma è iniettato in un uovo. Incubatrici per uova.

RFJKF6W1–La fertilizzazione in vitro , iniezione di sperma nella cellula uovo , assistito Trattamento riproduttivo

RF2AF68Y0–In vitro antico motto latino significato - in vetro; il processo biologico che si verifica in laboratorio, combinato su vintage verniciato superficie in legno

RME5RY4N–Immagine concettuale che rappresenta la fertilizzazione in vitro (IVF), mostrando i neonati in tubi di prova.

RF2DHMGRK–Fertilizzazione in vitro (IVF). Primo piano di fusione di sperma e ovume. Rimuovere un ovulo dalle ovaie della donna

RMMA98B3–Fotografia del dottor Davis Lupo, un microbiologo a lavorare presso la CDC e Lee Lam, NCHHTSP entrambi membri del personale che lavorano in un contesto di laboratorio indossando indumenti di protezione accanto a macchine, usando un luminometro per misurare l infezione da HIV delle cellule umane in vitro, 2007. Immagine cortesia CDC/Hsi Liu, James Gathany. ()

RFR4XXGX–IVF baby concetto e fecondazione in vitro in trattamento per la fertilità e la fecondazione artificiale come un simbolo con un feto in un tubo di prova di aiutare.

RFKDG9N2–La fecondazione in vitro concetto. Computer illustrazione che mostra spermatozoans in una capsula di petri in attesa di essere usato per fertilizzare una cellula uovo.

RMBM6006–Clinica privata per la fecondazione in vitro. La fecondazione artificiale. Lo sperma è iniettato in un uovo. Incubatrici per uova.

RFPA4TRY–La fertilizzazione in vitro , iniezione di sperma nella cellula uovo, assistito Trattamento riproduttivo

RF2HX495G–Concetto di carne coltivata a cellule in laboratorio per la produzione artificiale in vitro con carne macinata cruda confezionata con labe confezionata

RM2GF609Y–Billboard pubblicizza una clinica IVF (in vitro Fertilization) nella periferia di Melbourne, Australia. I ritratti del personale evidenziano la diversità etnica

RFW7808F–Chiara piatto di IVF e narishigi su di esso nel laboratorio della fecondazione in vitro . Primo piano con il fuoco selettivo. Orizzontale.

RME5RXY8–Un tecnico sta utilizzando un microscopio a luce per selezionare uova umano (Ovum) per la fecondazione in vitro, la procreazione medicalmente assistita

RM3DE5W49–Un medico della fecondazione in vitro che lavora con spermatozoi ed emryos per la fecondazione in vitro (IVF) e l'assitanza delle gravidanze.

RF2BTT980–Materiale per un esperimento di ricerca in vitro: Capsule di petri contenenti terreno di coltura, pinzette, micropipette e sterilizzatore automatico

RF2DHXY2D–Plasma ricco di piastrine. Strati di sangue in una provetta di vetreria. Provetta per analisi con PRP. In vitro.

RFR4M716–La fecondazione in vitro o FIVET trattamento per la fertilità e la fecondazione artificiale con un essere umano cellula uovo e sperma aiutare con i problemi di infertilità.

RFKDG9MY–La fecondazione in vitro concetto. Computer illustrazione che mostra spermatozoans in una capsula di petri in attesa di essere usato per fertilizzare una cellula uovo.

RMBM5YYR–Clinica privata per la fecondazione in vitro. La fecondazione artificiale. Lo sperma è iniettato in un uovo, da micro aghi, microscopio
RF2XY0JRF–Fecondazione in vitro, provetta per test icona bambino. Sperma in matraccio, simbolo del vettore di bioingegneria.

RF2J2ENMP–Concetto di carne coltivata a cellule in laboratorio per la produzione artificiale in vitro con carne macinata cruda confezionata con labe confezionata

RF2AB01XX–In vitro la carne, cresciuto in tubi. La carne di maiale in imballaggi pronti per la vendita.

RFW7809D–IVF il piatto con gocce di materiale e narishigi su di esso nel laboratorio della fecondazione in vitro . Foto macro con messa a fuoco selettiva. Orizz.

RME5RXYE–Tecnico in una fertilizzazione in vitro (IVF) clinica esaminando gli embrioni sotto un microscopio, la procreazione medicalmente assistita

RMCRHPGC–Clinica di fertilità campione di fertilizzazione in vitro lab uovo ivf assistente medico embrione incubazione
RF2S9T17M–Spermatozoi congelati in un contenitore per inseminazione artificiale o per la fecondazione in vitro, illustrazione del simbolo dell'icona

RF3BK34KF–Tecnologia riproduttiva assistita. Fecondazione in vitro. Inseminazione intrauterina e iniezione intracitoplasmatica di spermatozoi. trattamento per la fertilità. Detaile

RFR6C6HG–La modifica genetica domande e ricerca genetica in vitro ingegneria genomica e biotecnologia medica come CRISPR health care concetto.

RFKDG9N1–La fecondazione in vitro concetto. Computer illustrazione che mostra spermatozoans in una capsula di petri in attesa di essere usato per fertilizzare una cellula uovo.

RMBM5YR4–Clinica per la fecondazione in vitro. La fecondazione artificiale. Lo sperma è iniettato in un uovo. Lo sperma è conservata in azoto liquido.

RM2XCDMG7–St. Paul, Minnesota. il campidoglio. Sono con gli adesivi della genitorialità pianificati messi fuori durante un raduno di fertilizzazione in vitro.

RF2J829K0–Concetto di carne coltivata a cellule in laboratorio per la produzione artificiale in vitro con carne macinata cruda confezionata sul lato di sfondo rosso

RM3DE5W4C–Un medico della fecondazione in vitro che lavora con spermatozoi ed emryos per la fecondazione in vitro (IVF) e l'assitanza delle gravidanze.

RF2BTT987–Materiale per un esperimento di ricerca in vitro: Capsule di petri contenenti terreno di coltura e forcipe

RME5RXYD–Tecnico in una fertilizzazione in vitro (IVF) clinica esaminando gli embrioni sotto un microscopio, la procreazione medicalmente assistita

RMCRHP02–Clinica di fertilità campione di fertilizzazione in vitro di sperma di laboratorio medico di ivf centrifuga di lavaggio

RF2ARTG5K–Micropiante clonate in provette con terreno nutriente. Tecnologia di micropropagazione in vitro.
RF2TB74K3–Icona del vettore dello sperma e dell'iniezione o della siringa. Fecondazione in vitro, simbolo dello spermatozono.

RF2RE1FE7–Carne di laboratorio e bistecche coltivate in laboratorio come carni coltivate o coltivate a cellule e alimenti in vitro e alimenti protien alternativi con biotecnologia

RMBM606J–Clinica privata per la fecondazione in vitro. La fecondazione artificiale. Lo sperma è iniettato in un uovo, da micro aghi, microscopio

RF2HTPKJ9–Concetto di pesce di salmone coltivato a cellule coltivate in laboratorio per la produzione artificiale di pesce in vitro con pesce crudo congelato imballato con etichetta composta

RM2XCDMET–St. Paul, Minnesota. il campidoglio. Sono con gli adesivi della genitorialità pianificati messi fuori durante un raduno di fertilizzazione in vitro.

RF2WANJCW–Medico in laboratorio. Processo di inseminazione dell'uovo da parte dell'embriologo nel laboratorio della fecondazione in vitro.

RMECE74C–Concetto di fecondazione in vitro – lo sperma che forma le lettere della fecondazione in vitro rappresenta la fecondazione in vitro, la tecnologia riproduttiva e il trattamento della fertilità

RM3DE5W09–Un medico della fecondazione in vitro che lavora con spermatozoi ed emryos per la fecondazione in vitro (IVF) e l'assitanza delle gravidanze.

RF2BTT98C–Materiale per un esperimento di ricerca in vitro: Capsule di petri contenenti terreno di coltura, forcipe e micropipetta

RME5RXY5–Medico di eseguire una puntura follicule al raccolto uovo umano (oocita) per la fecondazione in vitro, la procreazione medicalmente assistita

RMCRHNXY–Clinica di fertilità campione di fertilizzazione in vitro di sperma di laboratorio medico di ivf macchina centrifuga

RMKT66AM–La frase "test Tube Babies (1948)" si riferisce alle prime nascite in vitro (fecondazione in vitro) e ai progressi medici nella tecnologia riproduttiva. La visita del medico si riferisce probabilmente al momento storico della sperimentazione della fecondazione in vitro.
RF2WHRHRH–Set di icone del vettore dello sperma nella provetta di analisi. Icone della vetreria in vitro e da laboratorio.

RF2R9CE7F–Pollo prodotto in laboratorio e carne coltivata in laboratorio come carne coltivata o coltivata a cellule e alimenti in vitro e alimenti prozieni alternativi con scien biotecnologico

RMBM5YPY–Clinica per la fecondazione in vitro. La fecondazione artificiale. Lo sperma è iniettato in un uovo. Lo sperma è conservata in azoto liquido.